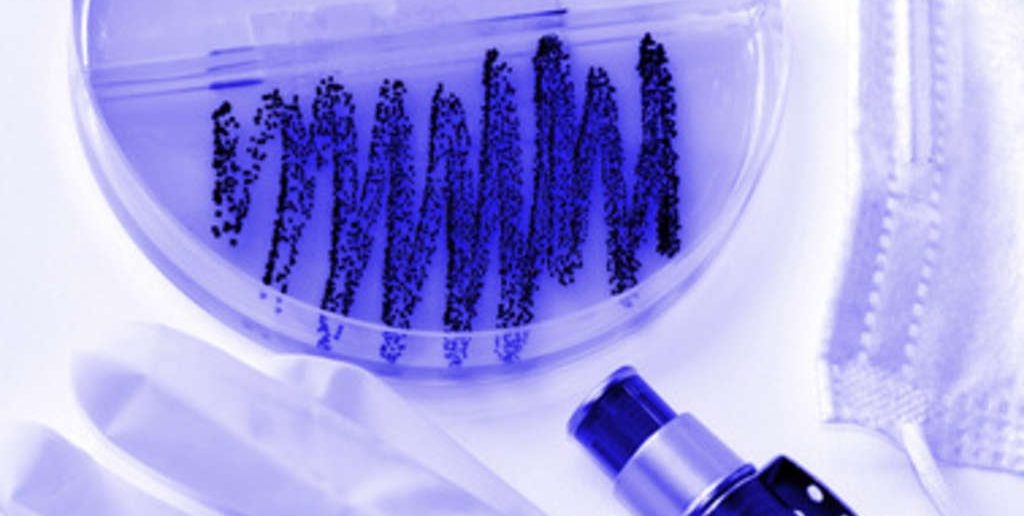
Nekrotisierende Fasciitis als Folge des Diabetes mellitus

Infolge eines durch Diabetes Mellitus geschwächten Immunsystems können Streptokokkeninfektionen auftreten, die in seltenen Fällen die Hautinfektion „Nekrotisierende Fasciitis“ auslösen können.
(Erfahren Sie hier alles über Risikofaktoren für die Gesundheit)
Typische Erkrankungen, die durch Streptokokken hervorgerufen werden, sind Scharlach und Mandelentzündungen. Doch gibt es auch eine Hautinfektion, die zum Absterben der Haut führen kann. Es ist eine sehr seltene Erkrankung (4 von 1.000.000 erkranken) aber sehr aggressiv verlaufend, sodass schnell gehandelt und behandelt werden muss.
Wie kommt es zu einer Infektion?
Durch eine kleine Verletzung der Haut können die Streptokokken in das Bindegewebe eindringen: Beispielsweise Insektenstiche oder kleine Kratzer an der Haut sind der Auslöser. Die perlenkettenförmigen Streptokokken oder die Staphylokokken (als Keim des MRSA1 bekannt) greifen die Haut, die Unterhaut und die Fascien, also die Muskelhülle, an.
Welche Symptome treten auf?
Zu den Symptomen zählen zunächst Fieberschübe und Gliederschmerzen. Dann folgen lokale Schmerzen – durch Ischämie der Faszien hervorgerufen – Veränderungen der Haut, Schwellung durch Gewebsödem, Erythem, rote und lila Verfärbungen und Blasenbildung. In manchen Fällen kann es sogar zu einer begleitenden Blutvergiftung kommen.
Wer ist besonders anfällig für eine solche Infektion?
Besonders anfällig für diese Erkrankung sind diejenigen, die ein geschwächtes Immunsystem haben. Was schwächt mein Immunsystem besonders? Hierzu zählen:
– fortgeschrittenes Alter
– Diabetis mellitus
– Arterielle Verschlußkrankheiten
– Chronischer Alkoholmissbrauch
– intravenöser Drogenmissbrauch
– Immunsuppression durch beispielsweise Chemotherapeutika
Wie wird behandelt?
Das befallene Gewebe muss chirurgisch vollständig abgetragen werden, gegebenfalls müssen Gliedmaßen sogar amputiert werden. Wichtig ist, dass nicht nur das nekrotische Gewebe entfernt wird, sondern auch die toxischen „Abfallprodukte“. Wenn nicht radikal und aggressiv abgetragen wird, steigt die Sterberate auf 85-100 %.
Angi Peukert
Quellenangaben:
1. http://www.aerzteblatt.de/pdf/95/8/a408-3.pdf
2. http://www.focus.de/gesundheit/ratgeber/seltenekrankheiten/tid-22787/nekrotisierende-fasziitis-radikale-chirurgische-therapie_aid_641237.html